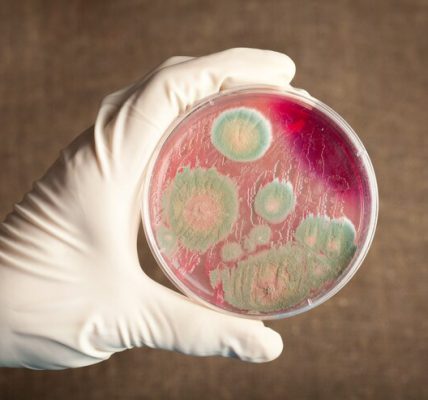

Çinko, vücudumuz için hayati öneme sahip olan bir eser mineraldir. Proteinlerin sentezlenmesi, bağışıklık sisteminin güçlenmesi, yara iyileşmesi gibi birçok biyolojik süreçte rol oynar. İnsan vücudu çinko üretemediği veya depolayamadığı için, günlük olarak besinlerden alınması gerekir.
Çinko Neden Önemlidir?
1. Bağışıklık Sisteminin Desteklenmesi:
Çinko, bağışıklık hücrelerinin üretilmesi ve enfeksiyonlara karşı savaşması için gereklidir. Çinko eksikliği, sık sık hasta olmanıza neden olabilir. Özellikle grip ve soğuk algınlığı dönemlerinde çinko alımı önemlidir.
2. Hücre Yenilenmesi:
Çinko, DNA sentezi ve hücre bölünmesinde kritik bir rol oynar. Bu nedenle, vücudun büyüme, gelişme ve yaraların iyileşmesi süreçlerinde aktif olarak kullanılır.
3. Cilt Sağlığı:
Çinko, akne tedavisinde sıkça kullanılan bir mineraldir. Aynı zamanda cilt yenilenmesini destekler ve egzama gibi cilt hastalıklarının tedavisinde faydalıdır.
4. Tat ve Koku Alma:
Çinko eksikliği, tat ve koku alma duyularında azalmaya neden olabilir. Çinko, tat alma tomurcuklarının çalışmasında önemli bir role sahiptir.
Çinko Hangi Besinlerde Bulunur?
1. Et ve Deniz Ürünleri:
- Kırmızı et: Dana eti ve kuzu eti, çinko açısından oldukça zengindir.
- Deniz ürünleri: İstiridye, çinko içeriği bakımından en zengin besindir. Somon ve ton balığı gibi balıklar da iyi bir kaynaktır.
2. Süt ve Süt Ürünleri:
- Yoğurt, peynir ve süt gibi besinler hem çinko hem de kalsiyum açısından zengin birer kaynaktır.
3. Baklagiller ve Tahıllar:
- Mercimek, nohut ve fasulye gibi baklagiller çinko içerir. Tam buğday ekmeği ve kahverengi pirinç gibi tam tahıllar da çinko alımına katkıda bulunabilir. Ancak fitat içeriği yüksek olan bu besinler çinko emilimini azaltabilir.
4. Kuruyemişler ve Tohumlar:
- Kabak çekirdeği, kaju ve badem gibi kuruyemişler çinko deposudur. Aynı zamanda chia ve kenevir tohumu gibi seçenekler de tercih edilebilir.
5. Sebzeler ve Meyveler:
- Ispanak, brokoli, kuşkonmaz gibi sebzelerde çinko bulunur. Ancak sebzelerdeki çinko miktarı genellikle hayvansal gıdalara kıyasla daha düşüktür.
Çinko Eksikliği Belirtileri
Çinko eksikliği, dünyada yaygın bir sorun olup, şu belirtilerle kendini gösterebilir:
- Yavaş yara iyileşmesi,
- Sık sık enfeksiyon geçirme,
- Tat ve koku alma duyularında azalma,
- Saç dökülmesi,
- Ciltte kuruluk ve akne,
- Konsantrasyon eksikliği ve öğrenme güçlüğü.
Çinko eksikliği özellikle hamile kadınlar, emziren anneler, veganlar ve yaşlılarda daha sık görülür.
Günlük Çinko İhtiyacı
Çinko ihtiyacı, yaşa ve cinsiyete göre değişir. Ortalama olarak:
- Erkekler için: Günde 11 mg,
- Kadınlar için: Günde 8 mg,
- Hamile ve emziren kadınlar için: Günde 11-12 mg.
Bu ihtiyacı karşılamak için dengeli ve çeşitli bir beslenme düzeni oluşturulmalıdır.
Çinko Alımında Dikkat Edilmesi Gerekenler
- Takviye Kullanımı:
Çinko takviyeleri ihtiyaç durumunda kullanılabilir, ancak fazla çinko alımı mide bulantısı, baş ağrısı ve bağışıklık sisteminin baskılanması gibi yan etkilere neden olabilir. Günlük üst sınır yetişkinler için 40 mg’dır. - Fitatlara Dikkat:
Tahıllar ve baklagillerde bulunan fitatlar, çinkonun emilimini engelleyebilir. Bu nedenle, çinko içeren yiyecekleri C vitamini kaynaklarıyla tüketmek faydalı olabilir.
Çinko, yaşam kalitesini artıran ve vücudumuzun birçok temel fonksiyonunda rol oynayan bir mineraldir. Et, deniz ürünleri, süt ürünleri, kuruyemişler ve tahıllar gibi çeşitli besinleri tüketerek çinko ihtiyacınızı karşılayabilirsiniz. Dengeli bir beslenme ile hem fiziksel hem de zihinsel sağlığınızı destekleyebilirsiniz.